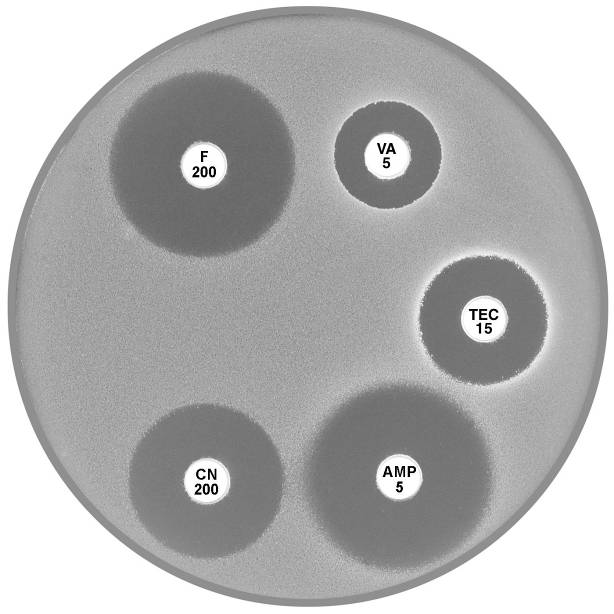
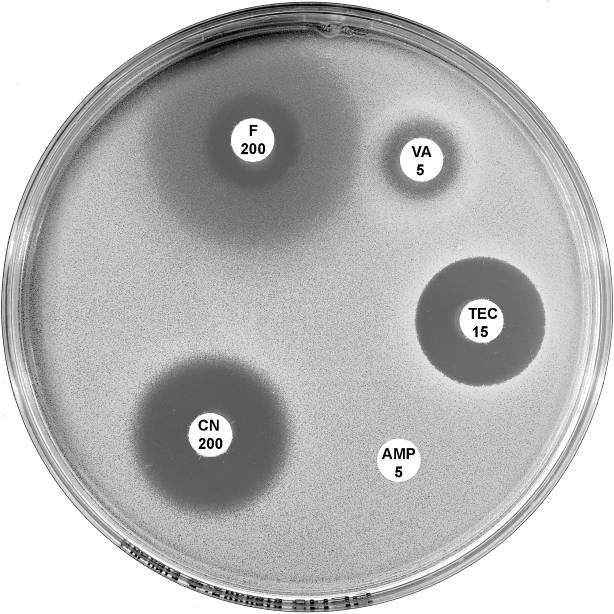
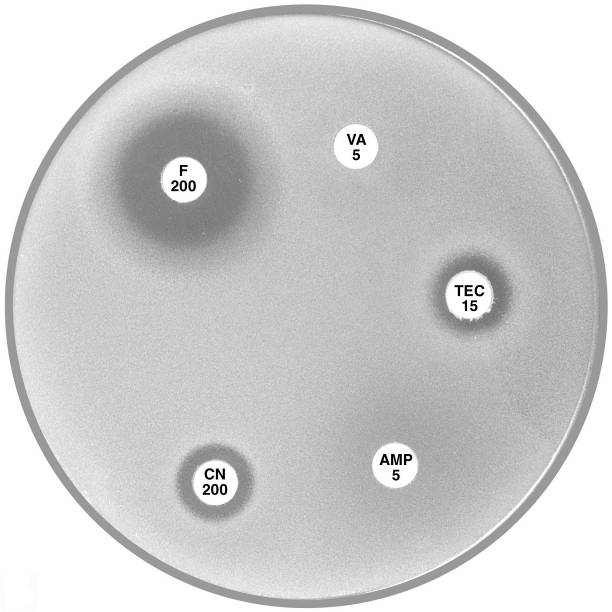
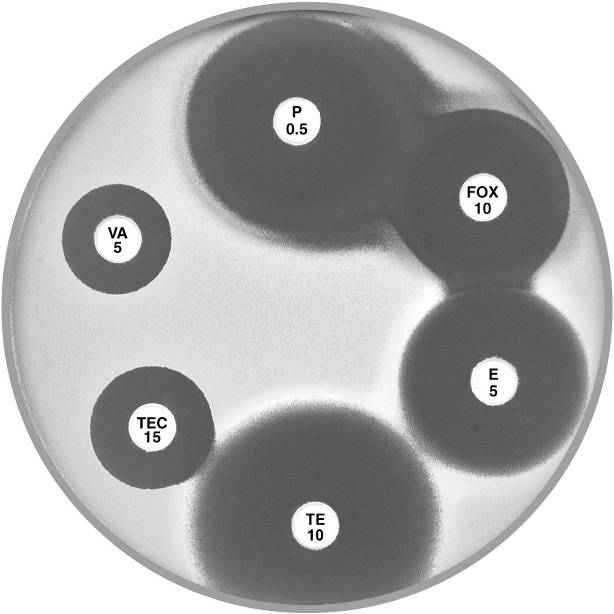
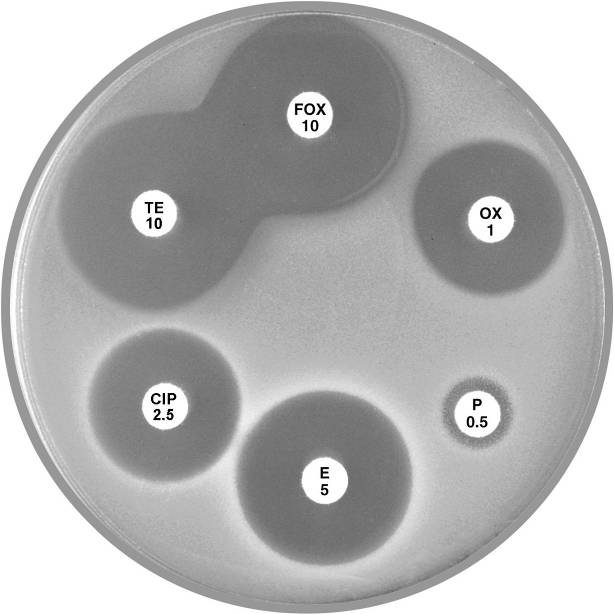
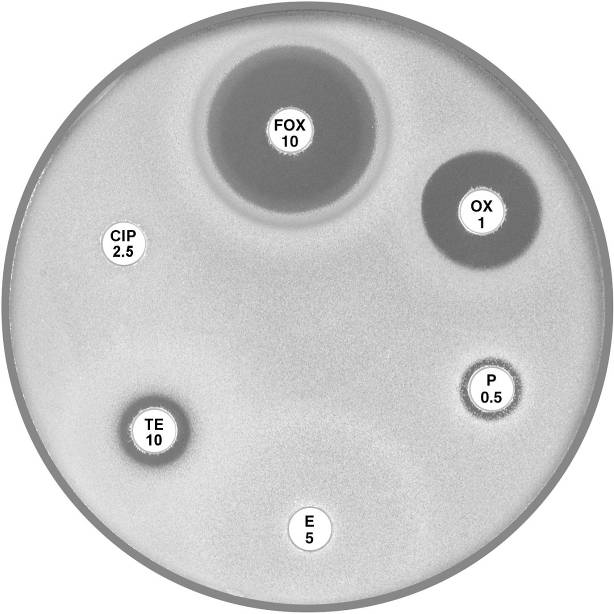
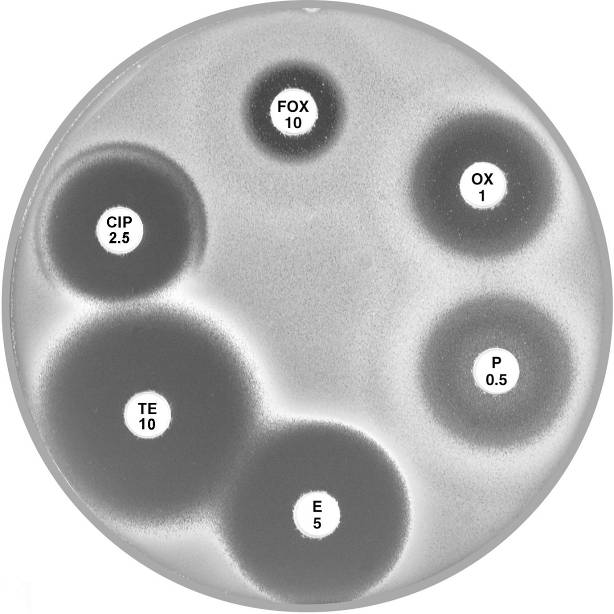
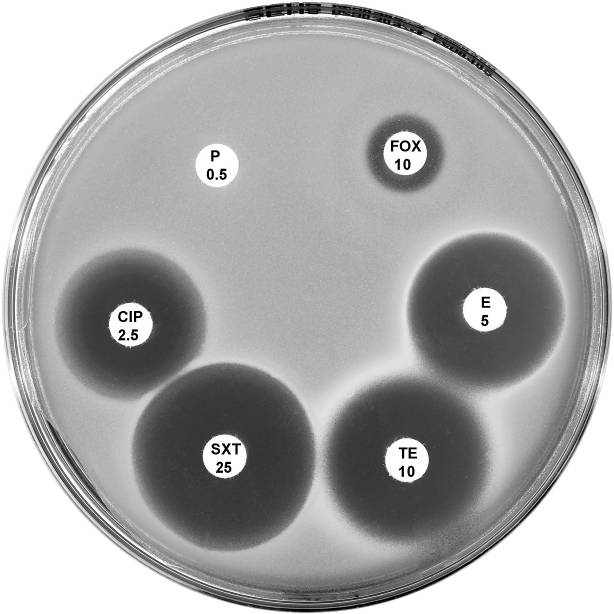
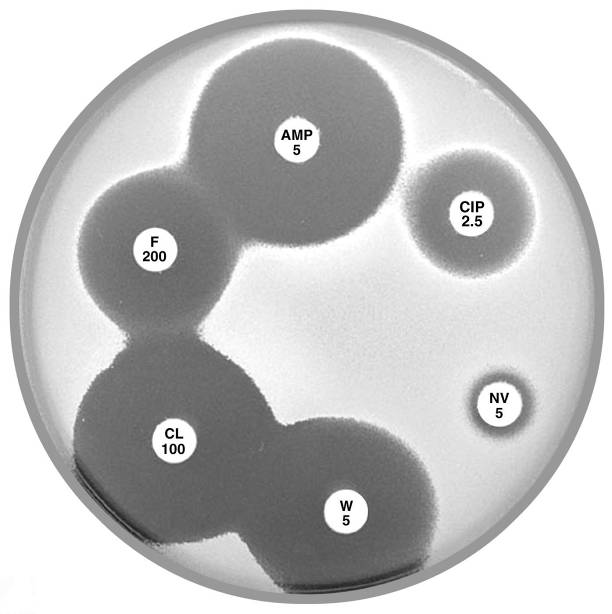
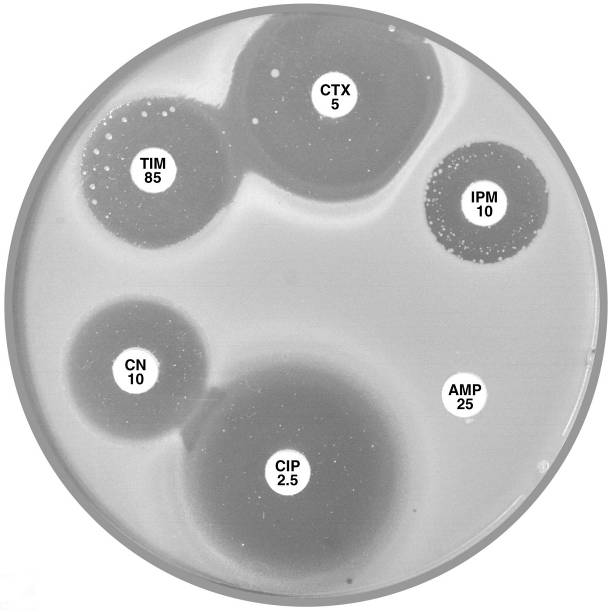
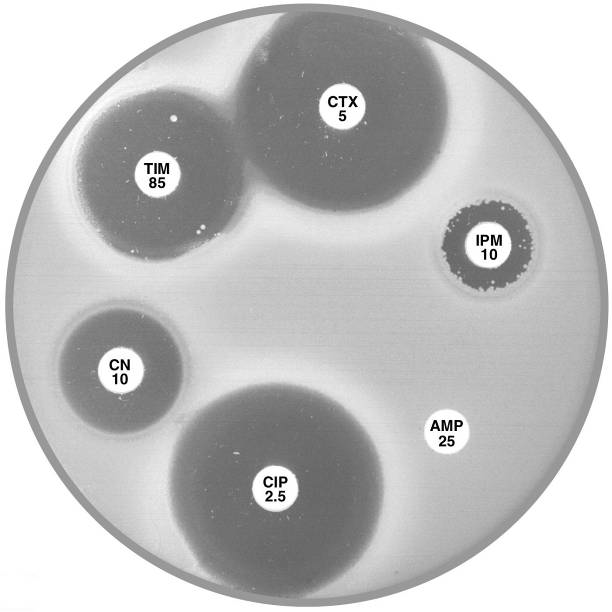
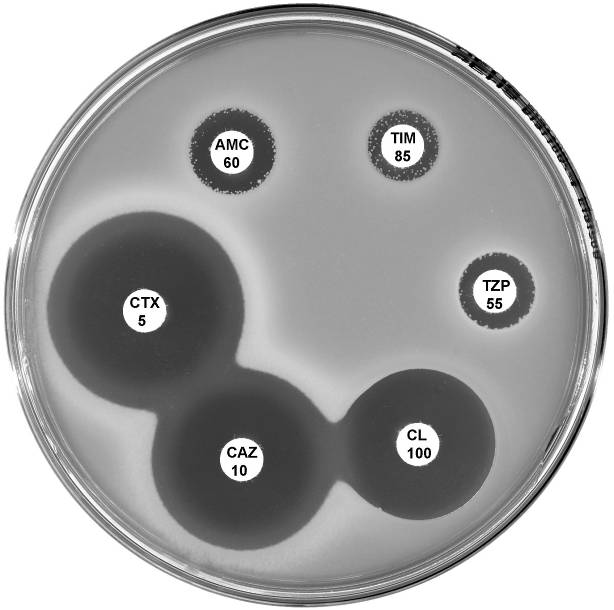
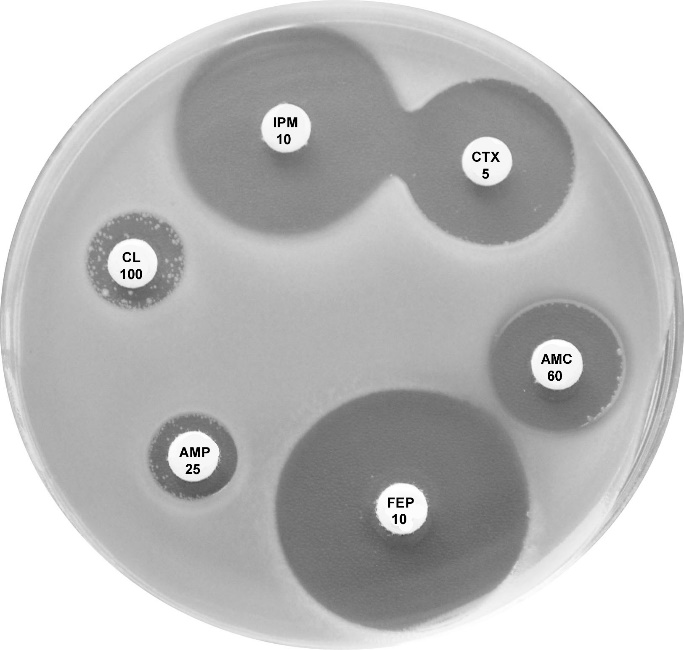
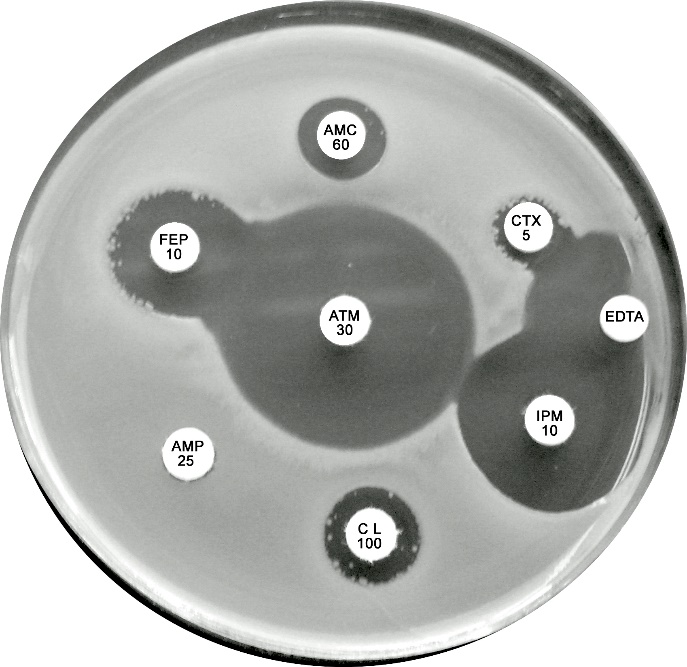
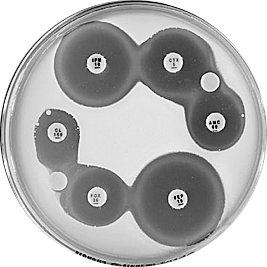
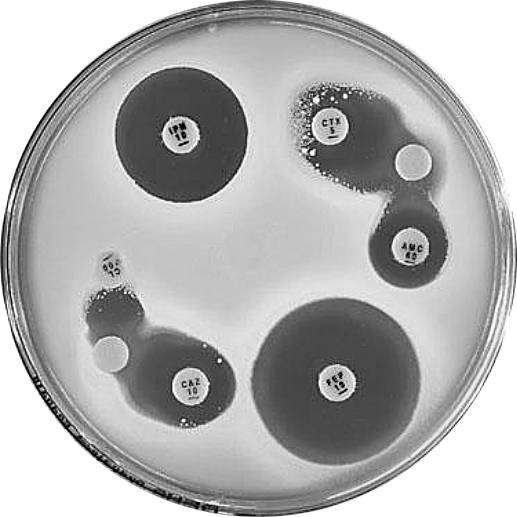
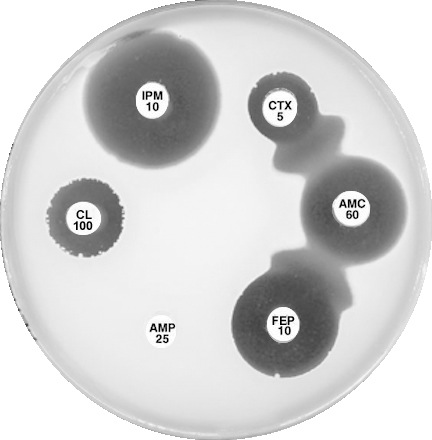
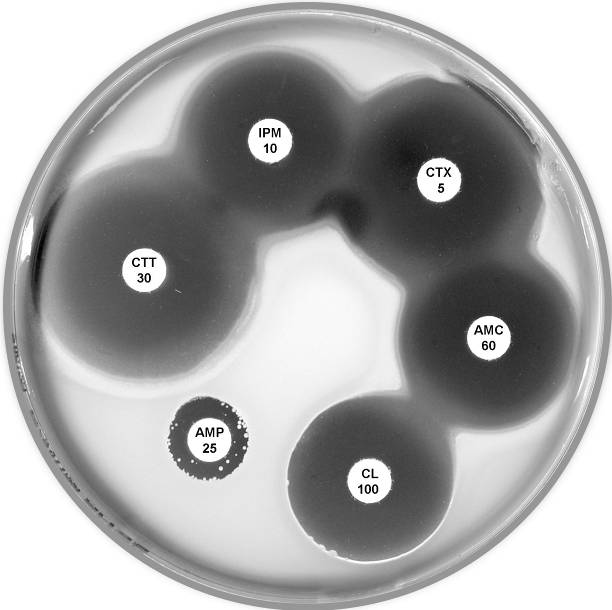
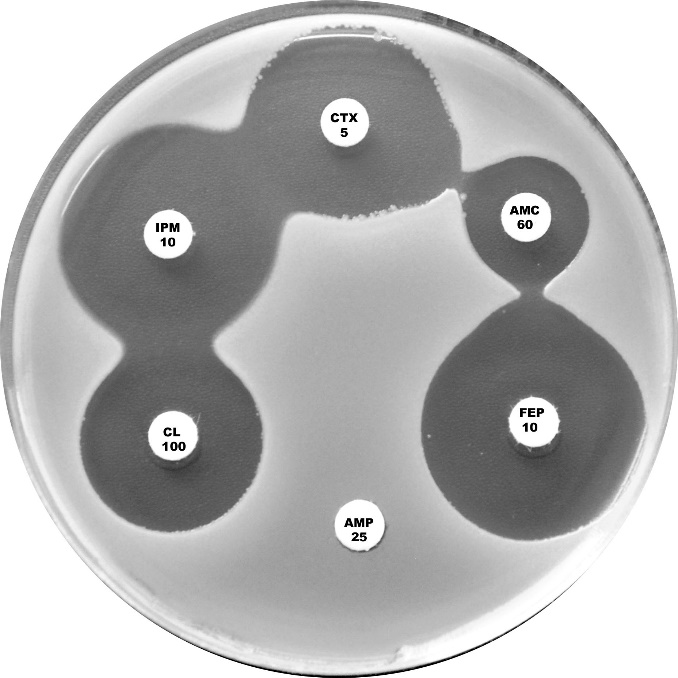
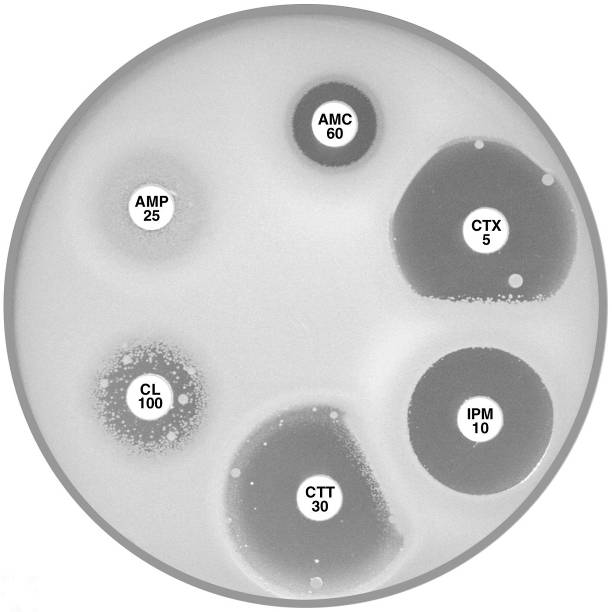
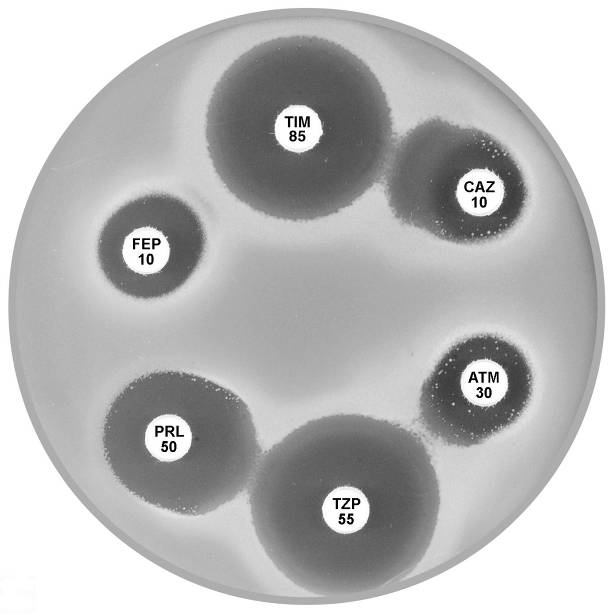
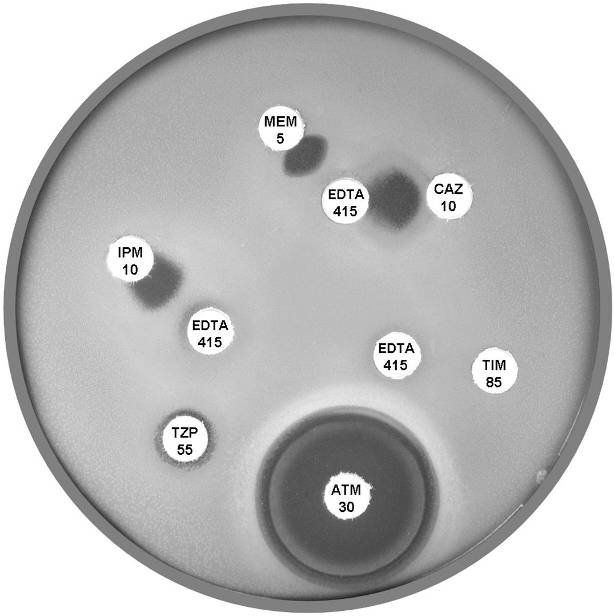
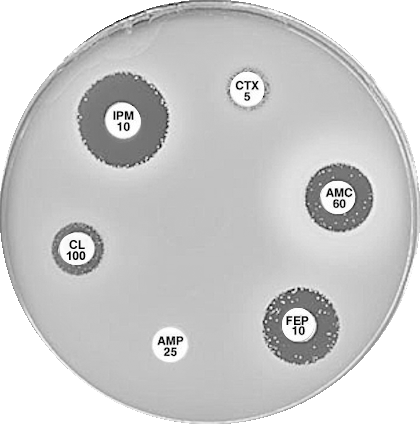
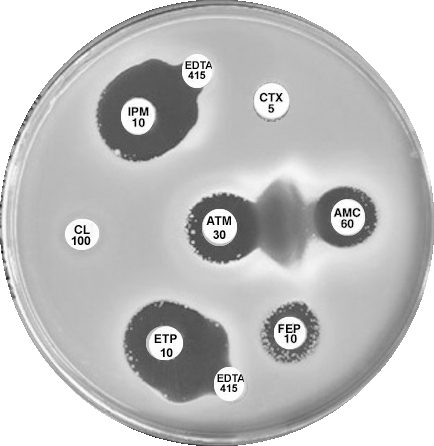
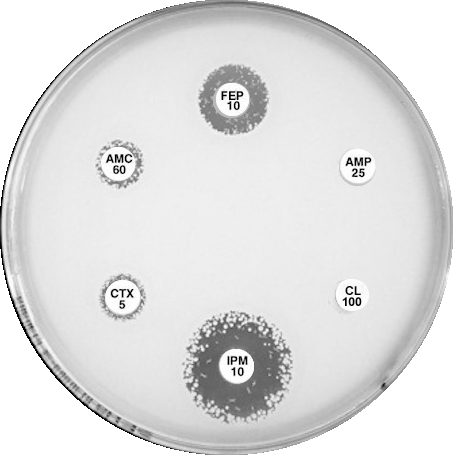
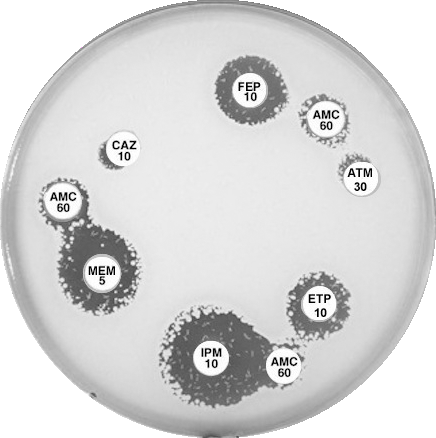

12 Plates
12.1 Enterococcus faecalis, Enterococcus faecium
|
 |
Plate 12.1.A Enterococcus faecalis and ampicillin The diffuse edge to the zone of inhibition > 4 mm around ampicillin (AMP 5) indicates susceptibility. |
Plate 12.1.B Enterococcus faecalis producing β-lactamase The sharp edge and the reduced inhibitory zone around ampicillin (AMP 5) indicate β-lactamase production and resistance. |
 |
|
Plate 12.1.C Enterococcus faecium and nitrofurantoin The hazy edged zone of inhibition around nitrofurantoin and no zone of inhibition around ampicillin is characteristic of E. faecium. |
12.2 Enterococcus faecium, Enterococcus gallinarum & Leuconostoc
|
|
Plate 12.2.A Enterococcus faecium with VanB type vancomycin resistance The hazy edged inhibitory zone around vancomycin (VA 5) and the diffuse growth towards the disc is frequently observed with this phenotype. |
Plate 12.2.B Enterococcus faecium with VanA type vancomycin resistance Resistance to both vancomycin (VA 5) and teicoplanin (TEC 15) is typical of the vanA phenotype. |
 |
 |
Plate 12.2.C Enterococcus gallinarum with intrinsic VanC type vancomycin resistance Note the sharp edge of the reduced inhibitory zone around vancomycin (VA 5). |
Plate 12.2.D Leuconostoc versus vancomycin and teicoplanin This organism has high inherent resistance to vancomycin (VA 5) and teicoplanin (TEC 15). |
12.3 Staphylococcus aureus
|
 |
Plate 12.3.A Staphylococcus aureus ATCC 9144 (NCTC 6571) This organism is fully susceptible and has large inhibitory zones around penicillin (P 0.5), cefoxitin (FOX 10), vancomycin (VA 5) and teicoplanin (TEC 15); 12 mm, 10 mm, 3 mm and 5 mm respectively. |
Plate 12.3.B Staphylococcus aureus with low β-lactamase activity The reduced inhibitory zone around penicillin (P 0.5) with an annular radius of 4 to 5 mm indicates resistance to penicillin. The sharp edge of the inhibitory zone confirms β-lactamase production. |
|
|
Plate 12.3.C Staphylococcus aureus resistant to penicillin only Note the 9 mm annular radius of the zone of inhibition around cefoxitin (FOX 10). |
Plate 12.3.D Staphylococcus aureus (MSSA) mecA gene negative multiresistant This isolate shows susceptibility to cefoxitin (FOX 10) and resistance to the other antibiotics tested. |
12.4 MRSA
|
|
Plate 12.4.A Staphylococcus aureus (nmMRSA) Non multiresistant, mecA gene positive but lacks β-lactamase activity This isolate is reported as resistant to methicillin and all other lactams. |
Plate 12.4.B Staphylococcus aureus (nmMRSA) This isolate is susceptible to erythromycin (E 5), tetracycline (TE 10), trimethoprim-sulfamethoxazole (SXT 25) and ciprofloxacin (CIP 2.5) but is reported as resistant to methicillin. |
 |
 |
Plate 12.4.C MRSA with reduced susceptibility to vancomycin (VISA/GISA) Note the reduced inhibitory zone around vancomycin (VA 5) and teicoplanin (TEC 15). |
Plate 12.4.D MRSA with inducible clindamycin resistance (ICR) Inducible clindamycin resistance (ICR) is indicated by the absence of an inhibitory zone around erythromycin (E 5) and a flattening of the clindamycin (DA 2) zone adjacent to the erythromycin disc. |
12.5 Staphylococcus saprophyticus
|
 |
Plate 12.5.A Staphylococcus saprophyticus mecA gene negative Typical of urinary isolates. Resistant to novobiocin (NV 5) but susceptible to ampicillin (AMP 5) and cephalexin (CL 100). |
Plate 12.5.B Staphylococcus saprophyticus mecA gene negative with an inducible β-lactamase Urinary isolate resistant to ampicillin (AMP 5) but susceptible to cephalexin (CL 100). |
 |
|
Plate 12.5.C Staphylococcus saprophyticus mecA gene positive Urinary isolate showing resistance to ampicillin (AMP 5) and cephalexin (CL 100). |
12.6 Acinetobacter
 |
 |
Plate 12.6.A Acinetobacter lwoffi A large inhibitory zone around ampicillin (AMP 25), a smaller one around cephalexin (CL 100), resistance to trimethoprim (W 5) and a lack of synergy with sulphonamide (SXT 25) are typical of A. lwoffi |
Plate 12.6.B Acinetobacter baumannii Note the large inhibitory zone around amoxycillin-clavulanic acid (AMC 60), a small one around ampicillin (AMP 25) and none around cephalexin (CL 100). |
12.7 Aeromonas
|
|
Plate 12.7.A Aeromonas hydrophilia with cephalosporinase A1 & carbapenemase A2 The flattening of the inhibitory zone around cefotaxime (CTX 5) indicates an inducible A1 cephalosporinase. The reduced inhibitory zone around imipenem (IPM 10) with resistant colonies indicates an A2 carbapenemase. |
Plate 12.7.B Aeromonas sobria with carbapenemase A2 but lacking cephalosporinase A1 The A2 carbapenemase is indicated by the small inhibitory zone around imipenem (IPM 10) and resistant colonies within this zone. |
12.8 Escherichia coli
 |
|
Plate 12.8.A Escherichia coli ATCC 35218 producing TEM-1 β-lactamase This strain is resistant to ampicillin (AMP 25), but susceptible to amoxycillin-clavulanic acid (AMC 60), cefotaxime (CTX 5), imipenem (IPM 10), cefotetan (CTT 30) & cephalexin (CL 100). |
Plate 12.8.B Escherichia coli with an Inhibitor Resistant TEM (IRT) This isolate is resistant to the inhibiting effect of both clavulanic acid and tazobactam in amoxycillin-clavulanic acid, ticarcillin-clavulanic acid and piperacillin-tazobactam. The isolate remains susceptible to the cephalosporins. |
|
 |
Plate 12.8.C Escherichia coli with low activity of the AmpC β-lactamase Showing a zone inhibition >6mm around cefotaxime (CTX 5) and no zone around cephalexin (CL 100). |
Plate 12.8.D Escherichia coli with high activity of the AmpC β-lactamase Note the absence of an inhibitory zone around both cefotaxime (CTX 5) and cephalexin (CL 100). |
12.9 Escherichia coli and Chryseobacterium indologenes
|
 |
Plate 12.9.A. Escherichia coli producing a zinc metallo β-lactamase Showing resistance to cefotaxime (CTX), cefepime (FEP) and amoxycillin-clavulanic acid (AMC) but susceptible to aztreonam. The lack of synergy between AMC and CTX/FEP suggesting the absence of an ESBL. Note the inhibitory zone > 6mm around imipenem and the inhibition of β-lactamase activity by EDTA. |
Plate 12.9.B. Chryseobacterium indologenes Chryseobacterium showing susceptibility to trimethoprim-sulfamethoxazole (SXT 25) and resistance to ceftazidime (CAZ 10) and aminoglycosides (AK 30 and CN 10). This strain is susceptible to the tested quinolones. |
|
|
Plate 12.9.C. Escherichia coli plasmid mediated AmpC β-lactamase (low activity) Synergy observed between a BA 200 ug (BA, blank) disc and the -lactam discs, CL 100 (4 mm), AMC 60 (reduced) and CTX 5 (slightly reduced). - |
Plate 12.9.D. Escherichia coli plasmid mediated AmpC β-lactamase (higher activity) Synergy observed between a BA 200 g disc and the -lactam discs, CL 100 (no mm), AMC 60 (4mm), CAZ (4mm) and CTX 5 (numerous resistant colonies) |
12.10 Klebsiella pneumoniae
|
 |
Plate 12.10.A Klebsiella pneumoniae producing an ESBL ESBL production is indicated by the inhibition of the β-lactamase by clavulanic acid and the resulting “keyhole” inhibition pattern between cefotaxime, cefepime and amoxycillin-clavulanic acid. |
Plate 12.10.B Klebsiella pneumoniae producing a higher activity ESBL The higher level of ESBL production is indicated by the inhibition of the β-lactamase by clavulanic acid and the resulting elliptical inhibitory zone between cefotaxime and amoxycillin-clavulanic acid. |
12.11 Klebsiella oxytoca
|
 |
Plate 12.11.A Klebsiella oxytoca with a low basal level of K1 β-lactamase This isolate is resistant to ampicillin only. |
Plate 12.11.B Klebsiella oxytoca with a low basal level of K1 β-lactamase and an ESBL ESBL production is demonstrated by the “keyhole” and elliptical inhibitory zones between cephalexin (CL 100) and cefotaxime (CTX 5) respectively and amoxycillin-clavulanic acid (AMC 60). |
|
 |
Plate 12.11.C Klebsiella oxytoca with a moderate level of the K1 β-lactamase This isolate shows a mild synergy between cefotaxime (CTX 5)/cefepime (FEP 10) and amoxycillin-clavulanic acid (AMC 60). |
Plate 12.11.D Klebsiella oxytoca with a higher level of the K1 β-lactamase There is no obvious synergy between cephalexin (CL 100) or cefotaxime (CTX 5) and amoxycillin-clavulanic acid (AMC 60). |
12.12 Enterobacter and Citrobacter
|
 |
Plate 12.12.A Enterobacter cloacae with AmpC β-lactamase The flattened inhibitory zone around imipenem (IPM 10) adjacent to cefotaxime/cefotetan (CTX 5, CTT 30) demonstrates the presence of a basal inducible cephalosporinase. |
Plate 12.12.B Enterobacter cloacae producing higher levels of the AmpC β-lactamase and also an ESBL Note the resistance to cefotaxime (CTX 5) and cefotetan (CTT 30). |
 |
 |
Plate 12.12.C Citrobacter freundii with derepressed AmpC β-lactamase and ESBL The ESBL is indicated by the keyhole pattern between cefepime (FEP 10), aztreonam and amoxycillin-clavulanic acid (AMC 60) (ATM 30). AmpC derepression is indicated by the resistance to cefotetan (CTT 30). |
Plate 12.12.C Citrobacter freundii with derepressed AmpC β-lactamase Note the resistance to cefotaxime (CTX 5) and cefotetan (CTT 30). |
12.13 Proteus penneri
 |
 |
Plate 12.13.A Proteus penneri with an inducible group 2e β-lactamase. The large inhibitory zone around Amoxycillin-clavulanic acid (AMC 60) and the flattening of the cefotaxime (CTX 5) zone adjacent to imipenem (IPM 10) indicate the presence of an inducible Ambler class A (Bush group 2e) β-lactamase. |
Plate 12.13.B Proteus penneri with a derepressed group 2e β-lactamase. The susceptibility to ceftazidime and cefotetan, and the synergy between amoxycillin-clavulanic acid and cefotaxime suggest the presence of an Ambler class A (Bush group 2e) β-lactamase. The resistance to cefotaxime indicates hyper production of the β-lactamase. |
12.14 Pseudomonas aeruginosa
|
|
Plate 12.14.A Pseudomonas aeruginosa producing an ESBL Showing synergy between ticarcillin-clavulanic acid (TIM 85) & ceftazidime (CAZ 10) and between piperacillin-tazobactam (TZP 55) & aztreonam (ATM 30). |
Plate 12.14.B Pseudomonas aeruginosa producing a metallo β-lactamase (carbapenemase) Showing the inhibition of the carbapenemase by EDTA. |
12.15 Metallo β-lactamases (MBLs)
|
|
Plate 12.15.A K. pneumoniae producing an MBL on routine CDS test. Resistant to AMP 25, AMC 60, CTX 5, CL100 and FEP 10, colonies at the edge of imipenem (IPM 10) zone 6 mm, see sect. 5.5.8 |
Plate 12.15.B K. pneumoniae producing an MBL and an ESBL MBL because EDTA confirmatory test positive, ESBL because small ATM (aztreonam) with synergy between ATM and AMC (amoxycillin-clavulanic acid). |
12.16 K. pneumoniae carbapenemase (KPC)
|
|
Plate 12.16.A K. pneumoniae producing a KPC in routine CDS test. Resistant to all, numerous resistant colonies in imipenem (IPM) zone. Negative for ESBL and MBL. Perform confirmatory test for KPC |
Plate 12.16.B K. pneumoniae from Greece producing a KPC-2 Confirmatory test: Synergy between AMC 60 and IPM 10 hydrolyses carbapenem, a “super” ESBL. See Sect. 5.5.9 |
12.17 Stenotrophomonas maltophilia
 |
 |
Plate 12.17.A Stenotrophomonas maltophilia Note the lack of an inhibitory zone around imipenem, the pear shaped zone of inhibition between trimethoprim-sulfamethoxazole and trimethoprim and the resistant colonies within the ticarcillin-clavulanic acid and aztreonam inhibitory zones. |
Plate 12.17.B. Sulphonamide resistant Stenotrophomonas maltophilia No zone around trimethoprim-sulfamethoxazole (SXT 25). |